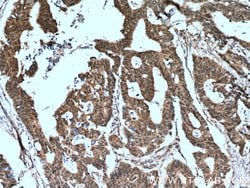
RANGRF Rabbit anti-Human, Mouse, Polyclonal, Proteintech 20 &mu;L; Unconjugated:Anticuerpos

missing translation for 'onlineSavingsMsg'
Learn More
Learn More
RANGRF Rabbit anti-Human, Mouse, Polyclonal, Proteintech
Rabbit Polyclonal Antibody
Marca: Proteintech 10552-1-AP-20UL
Este artículo no se puede devolver.
Vea la política de devoluciones
Descripción
May regulate the intracellular trafficking of RAN. In cardiac cells seems to regulate the cell surface localization of SCN5A.Especificaciones
| RANGRF | |
| Polyclonal | |
| Unconjugated | |
| RANGRF | |
| HSPC165, HSPC236, MDS5, MOG1, Ran binding protein MOG1, RANGNRF, RANGRF | |
| Rabbit | |
| Antigen Affinity Chromatography | |
| RUO | |
| 29098, 57785 | |
| -20°C | |
| Liquid |
| Immunohistochemistry (Paraffin), Immunocytochemistry, Western Blot, Immunofluorescence | |
| 0.27 mg/mL | |
| PBS with 50% glycerol and 0.1% sodium azide; pH 7.3 | |
| Q9HD47, Q9JIB0 | |
| RANGRF | |
| RANGRF Fusion Protein Ag0824 | |
| 20 μL | |
| Primary | |
| Human, Mouse | |
| Antibody | |
| IgG |
Corrección del contenido de un producto
Proporcione sus comentarios sobre el contenido del producto rellenando el siguiente formulario.
Título del producto
¿Detecta una oportunidad de mejora?Comparta una corrección de contenido